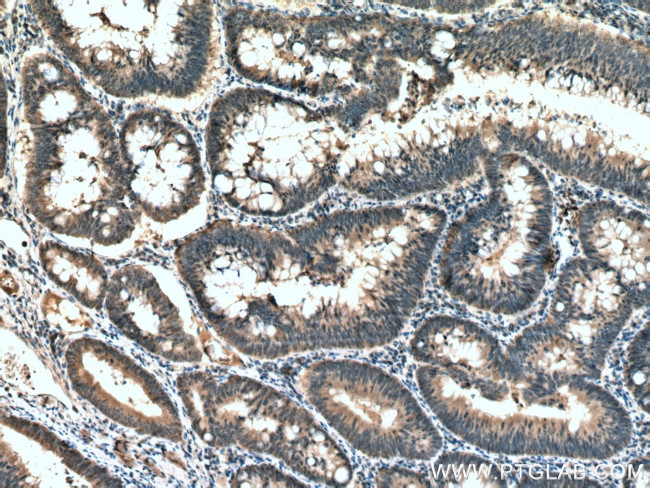
ATG5 Antibody in Immunohistochemistry (Paraffin) (IHC (P))

Search
Proteintech
ATG5 Monoclonal Antibody (2D3B8)
{{$productOrderCtrl.translations['antibody.pdp.commerceCard.promotion.promotions']}}
{{$productOrderCtrl.translations['antibody.pdp.commerceCard.promotion.viewpromo']}}
{{$productOrderCtrl.translations['antibody.pdp.commerceCard.promotion.promocode']}}: {{promo.promoCode}} {{promo.promoTitle}} {{promo.promoDescription}}. {{$productOrderCtrl.translations['antibody.pdp.commerceCard.promotion.learnmore']}}
产品信息
66744-1-IG
种属反应
宿主/亚型
分类
类型
克隆号
抗原
偶联物
形式
浓度
规格
纯化类型
保存液
内含物
保存条件
运输条件
产品详细信息
Immunogen sequence: TEREAEPYY LLLPRVSYLT LVTDKVKKHF QKVMRQEDIS EIWFEYEGTP LKWHYPIGLL FDLLASSSAL PWNITVHFKS FPEKDLLHCP SKDAIEAHFM SCMKEADALK HKSQVINEMQ KKDHKQLWMG LQNDRFDQFW AINRKLMEYP AEENGFRYIP FRIYQTTTER PFIQKLFRPV AADGQLHTLG DLLKEVCPSA IDPEDGEKKN QVMIHGIEPM LETPLQWLSE HLSYPDNFLH ISIIPQPTD (28-275 aa encoded by BC002699)
靶标信息
ATG5 (Autophagy Related 5) is an important element for autophagy and may play an important role in the apoptotic process. ATG5 is also involved in other cellular processes that include mitochondrial quality control after oxidative damage, negative regulation of the innate anti-viral immune response, lymphocyte development and proliferation, MHC II antigen presentation, and adipocyte differentiation. Following conjugation to ATG12, the conjugate participates in the formation of autophagosome. ATG5 contributes to autophagic cell death by interacting with Fas-associated protein with death domain (FADD). The ATG5-ATG12 conjugate forms a cup-shaped isolation membrane that then detaches from the membrane immediately before or after autophagosome formation is completed. APG5 may play a role in the apoptotic process, possibly within the modified cytoskeleton. Further, APG5 expression is a relatively late event in the apoptotic process, occurring downstream of caspase activity. The APG5-APG12 conjugate also associates with innate immune response proteins such as RIG-I and VISA (also known as IPS-1), inhibiting type I interferon production and permitting viral replication in host cells. Diseases associated with ATG5 dysfunction include spinocerebellar ataxia.
仅用于科研。不用于诊断过程。未经明确授权不得转售。
生物信息学
蛋白别名: alternatively spliced; APG 5; APG5; APG5 autophagy 5 like (APG5L); APG5 autophagy 5-like; APG5-like; Apoptosis-specific protein; Apoptosis-specific protein (ASP); AT5G17290; ATATG5; ATG5; ATG5 autophagy related 5 homolog; AUTOPHAGY 5; Autophagy protein 5; autophagy-related 5; MKP11.20; MKP11_20; similar to S. cerevisiae ATG5 autophagy related 5; unnamed protein product
基因别名: 2010107M05Rik; 3110067M24Rik; APG5; APG5-LIKE; APG5L; ASP; ATG5; Atg5l; AW319544; C88337; hAPG5; Paddy; SCAR25
UniProt ID: (Human) Q9H1Y0, (Mouse) Q99J83, (Rat) Q3MQ06
Entrez Gene ID: (Human) 9474, (Mouse) 11793, (Rat) 365601